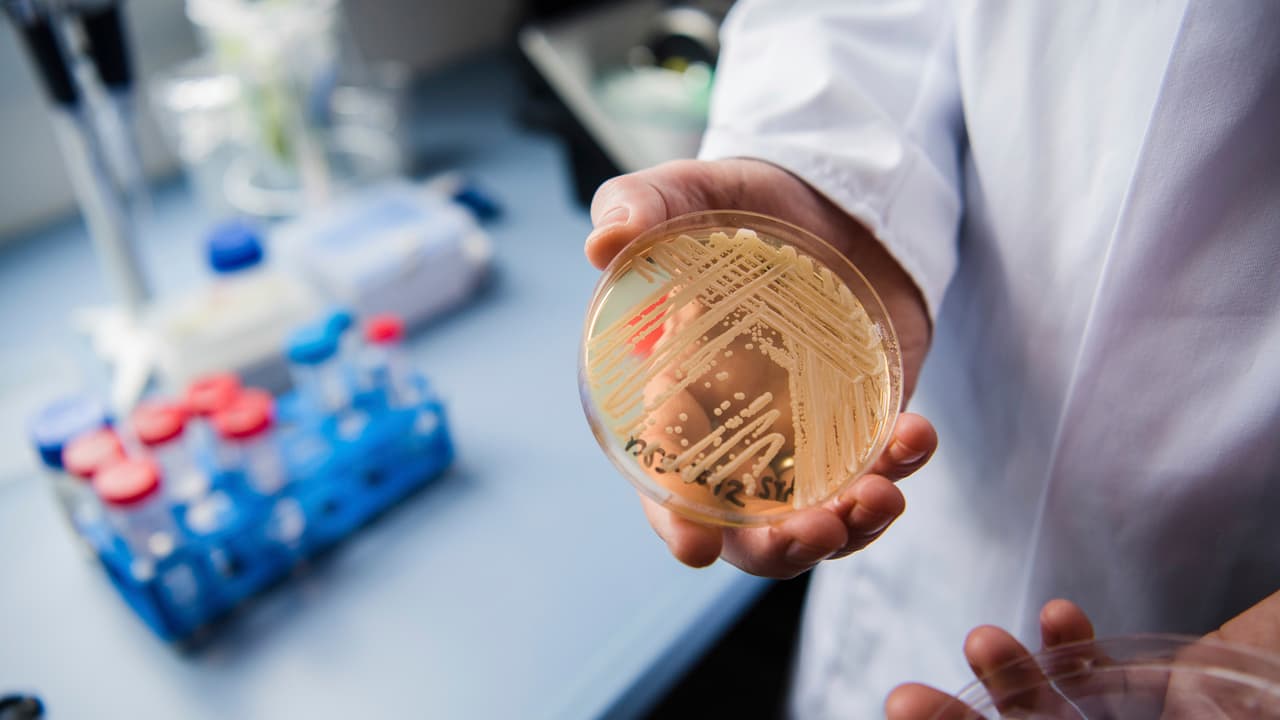
¿Qué es Candida auris y cómo se propaga? Experto habla sobre esta "superbacteria” resistente a los fármacos

Bacterias
Bacterias: Últimas noticias, videos y fotos de Bacterias
Nueva Jersey es uno de los estados afectados por el brote de salmonela vinculado a cebollas
Más de 650 personas en 37 estados se han enfermado por este brote de salmonela. Las autoridades recomiendan que, si no se sabe la procedencia de las cebollas, se tiren a la basura.
LO MÁS RECIENTE

Aumentan los casos de una extraña enfermedad transmitida por ratas en la ciudad de Nueva York
Funcionarios de salud advierten que este año hay más casos de leptospirosis humana, una extraña enfermedad que a veces no presenta síntomas, pero que si no se trata a tiempo, puede llevar a la muerte.

"Puede causar daños al cerebro”: advierte experta sobre alga en lagos de Austin
Una persona se enfermó tras nadar en el popular arroyo. Autoridades alertaron que las personas y las mascotas no deben ingerir ni entrar en contacto con el agua. Una doctora explica por qué.
Hongos y bacterias: todo lo que puedes encontrar en tu mascarilla si no lavas a menudo
Un reciente estudio reveló que los cubrebocas que no se lavan o desinfectan con frecuencia son una fuente de bacterias, hongos y otros patógenos. El doctor Kaseín González indicó que la falta de higiene con las mascarillas puede provocar infecciones cutáneas y problemas respiratorios que incluso pueden terminar en una neumonía.

Advierten que agua en popular arroyo de Austin no es segura para humanos y animales
Una persona se enfermó tras nadar en el popular arroyo. De acuerdo con autoridades, se alertó que las personas y las mascotas no deben ingerir ni entrar en contacto con el agua.
Al menos 16 escuelas en Plainfield continúan sin clases por problemas con el agua potable
El ayuntamiento de dicho poblado ha pedido a sus habitantes hervir el agua ante la posibilidad de que esta se encuentre contaminada con la bacteria E. coli. Lo anterior, luego de que se realizaran diversas pruebas realizadas por un laboratorio.

16 escuelas de Illinois retoman la educación a distancia por problemas con el agua
Plainfield, al suroeste de Chicago, permanece bajo una orden de hervir el agua o
boil order después de que se detectara la bacteria E. coli, según informaron las autoridades. Un total de 16 escuelas retoman este lunes la educación a distancia.